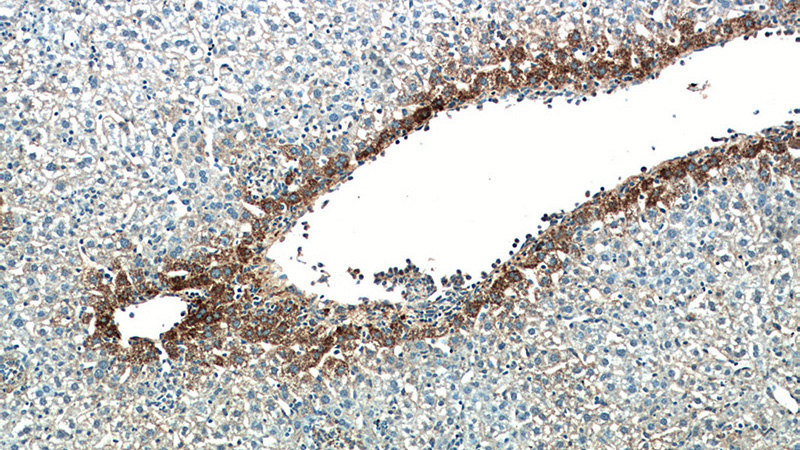
Immunohistochemical of paraffin-embedded mouse liver using Catalog No:109378(COL3A1 antibody) at dilution of 1:50 (under 10x lens)

-
Product Name
Collagen Type III antibody
- Documents
-
Description
Collagen Type III Rabbit Polyclonal antibody. Positive WB detected in mouse pancreas tissue, hVFFA8 cells, NIH/3T3 cells, rat aorta, rat pancreas tissue. Positive FC detected in HepG2 cells. Positive IHC detected in mouse liver tissue, human hepat℃irrhosis tissue. Positive IF detected in HepG2 cells. Observed molecular weight by Western-blot: 140 kDa; 170 kDa; 30 kDa
-
Tested applications
ELISA, IF, WB, IHC, FC
-
Species reactivity
Human,Mouse,Rat; other species not tested.
-
Alternative names
COL3A1 antibody; Collagen alpha 1(III) chain antibody; Collagen Type III antibody; collagen antibody; type III antibody; alpha 1 antibody; EDS4A antibody; FLJ34534 antibody
-
Isotype
Rabbit IgG
-
Preparation
This antibody was obtained by immunization of Collagen Type III recombinant protein (Accession Number: BC028178). Purification method: Antigen affinity purified.
-
Clonality
Polyclonal
-
Formulation
PBS with 0.02% sodium azide and 50% glycerol pH 7.3.
-
Storage instructions
Store at -20℃. DO NOT ALIQUOT
-
Applications
Recommended Dilution:
WB: 1:500-1:5000
IHC: 1:20-1:200
IF: 1:20-1:200
-
Validations

mouse pancreas tissue were subjected to SDS PAGE followed by western blot with Catalog No:109378(COL3A1 antibody) at dilution of 1:1000

WB result of Collagen Type III antibody (Catalog No:109378, 1:5000) with hVFFA8 cells lysate.
Immunohistochemical of paraffin-embedded mouse liver using Catalog No:109378(COL3A1 antibody) at dilution of 1:50 (under 10x lens)

Immunofluorescent analysis of HepG2 cells, using COL3A1 antibody Catalog No:109378 at 1:50 dilution and Rhodamine-labeled goat anti-rabbit IgG (red). Blue pseudocolor = DAPI (fluorescent DNA dye).

1X10^6 HepG2 cells were stained with 0.2ug COL3A1 antibody (Catalog No:109378, red) and control antibody (blue). Fixed with 90% MeOH blocked with 3% BSA (30 min). Alexa Fluor 488-congugated AffiniPure Goat Anti-Rabbit IgG(H+L) with dilution 1:1500.
-
Background
Type III collagen is a fibrillar forming collagen comprising three a1(III) chains and is expressed in early embryos and throughout embryogenesis. In the adult, type III collagen is a major component of the extracellular matrix in a variety of internal organs and skin. It occurs in most soft connective tissues along with type I collagen. COL3A1 gene encodes type III procollagen. Mutations in this gene are associated with type III and IV Ehlers-Danlos syndrome, and with aortic and arterial aneurysms. (PMID: 9050868; 2445760)
-
References
- Yang J, Zhu HH, Chen GP. Inhibition of farnesyl pyrophosphate synthase attenuates angiotensin II-induced cardiac hypertrophy and fibrosis in vivo. The international journal of biochemistry & cell biology. 45(3):657-66. 2013.
- Chen SX, Xu XE, Wang XQ. Identification of colonic fibroblast secretomes reveals secretory factors regulating colon cancer cell proliferation. Journal of proteomics. 110:155-71. 2014.
- Chuang TD, Pearce WJ, Khorram O. miR-29c induction contributes to downregulation of vascular extracellular matrix proteins by glucocorticoids. American journal of physiology. Cell physiology. 309(2):C117-25. 2015.
- Khorram O, Chuang TD, Pearce WJ. Long-term effects of maternal undernutrition on offspring carotid artery remodeling: role of miR-29c. Journal of developmental origins of health and disease. 6(4):342-9. 2015.
- Chuang TD, Khorram O. Mechanisms underlying aberrant expression of miR-29c in uterine leiomyoma. Fertility and sterility. 105(1):236-245.e1. 2016.
- Zhu L, Zhao S, Liu S, Liu Q, Li F, Hao J. PTEN Regulates Renal Extracellular Matrix Deposit via Increased CTGF in Diabetes Mellitus. Journal of cellular biochemistry. 117(5):1187-98. 2016.
- Dong Z, Zhao X, Tai W. IL-27 attenuates the TGF-β1-induced proliferation, differentiation and collagen synthesis in lung fibroblasts. Life sciences. 146:24-33. 2016.
Related Products / Services
Please note: All products are "FOR RESEARCH USE ONLY AND ARE NOT INTENDED FOR DIAGNOSTIC OR THERAPEUTIC USE"
